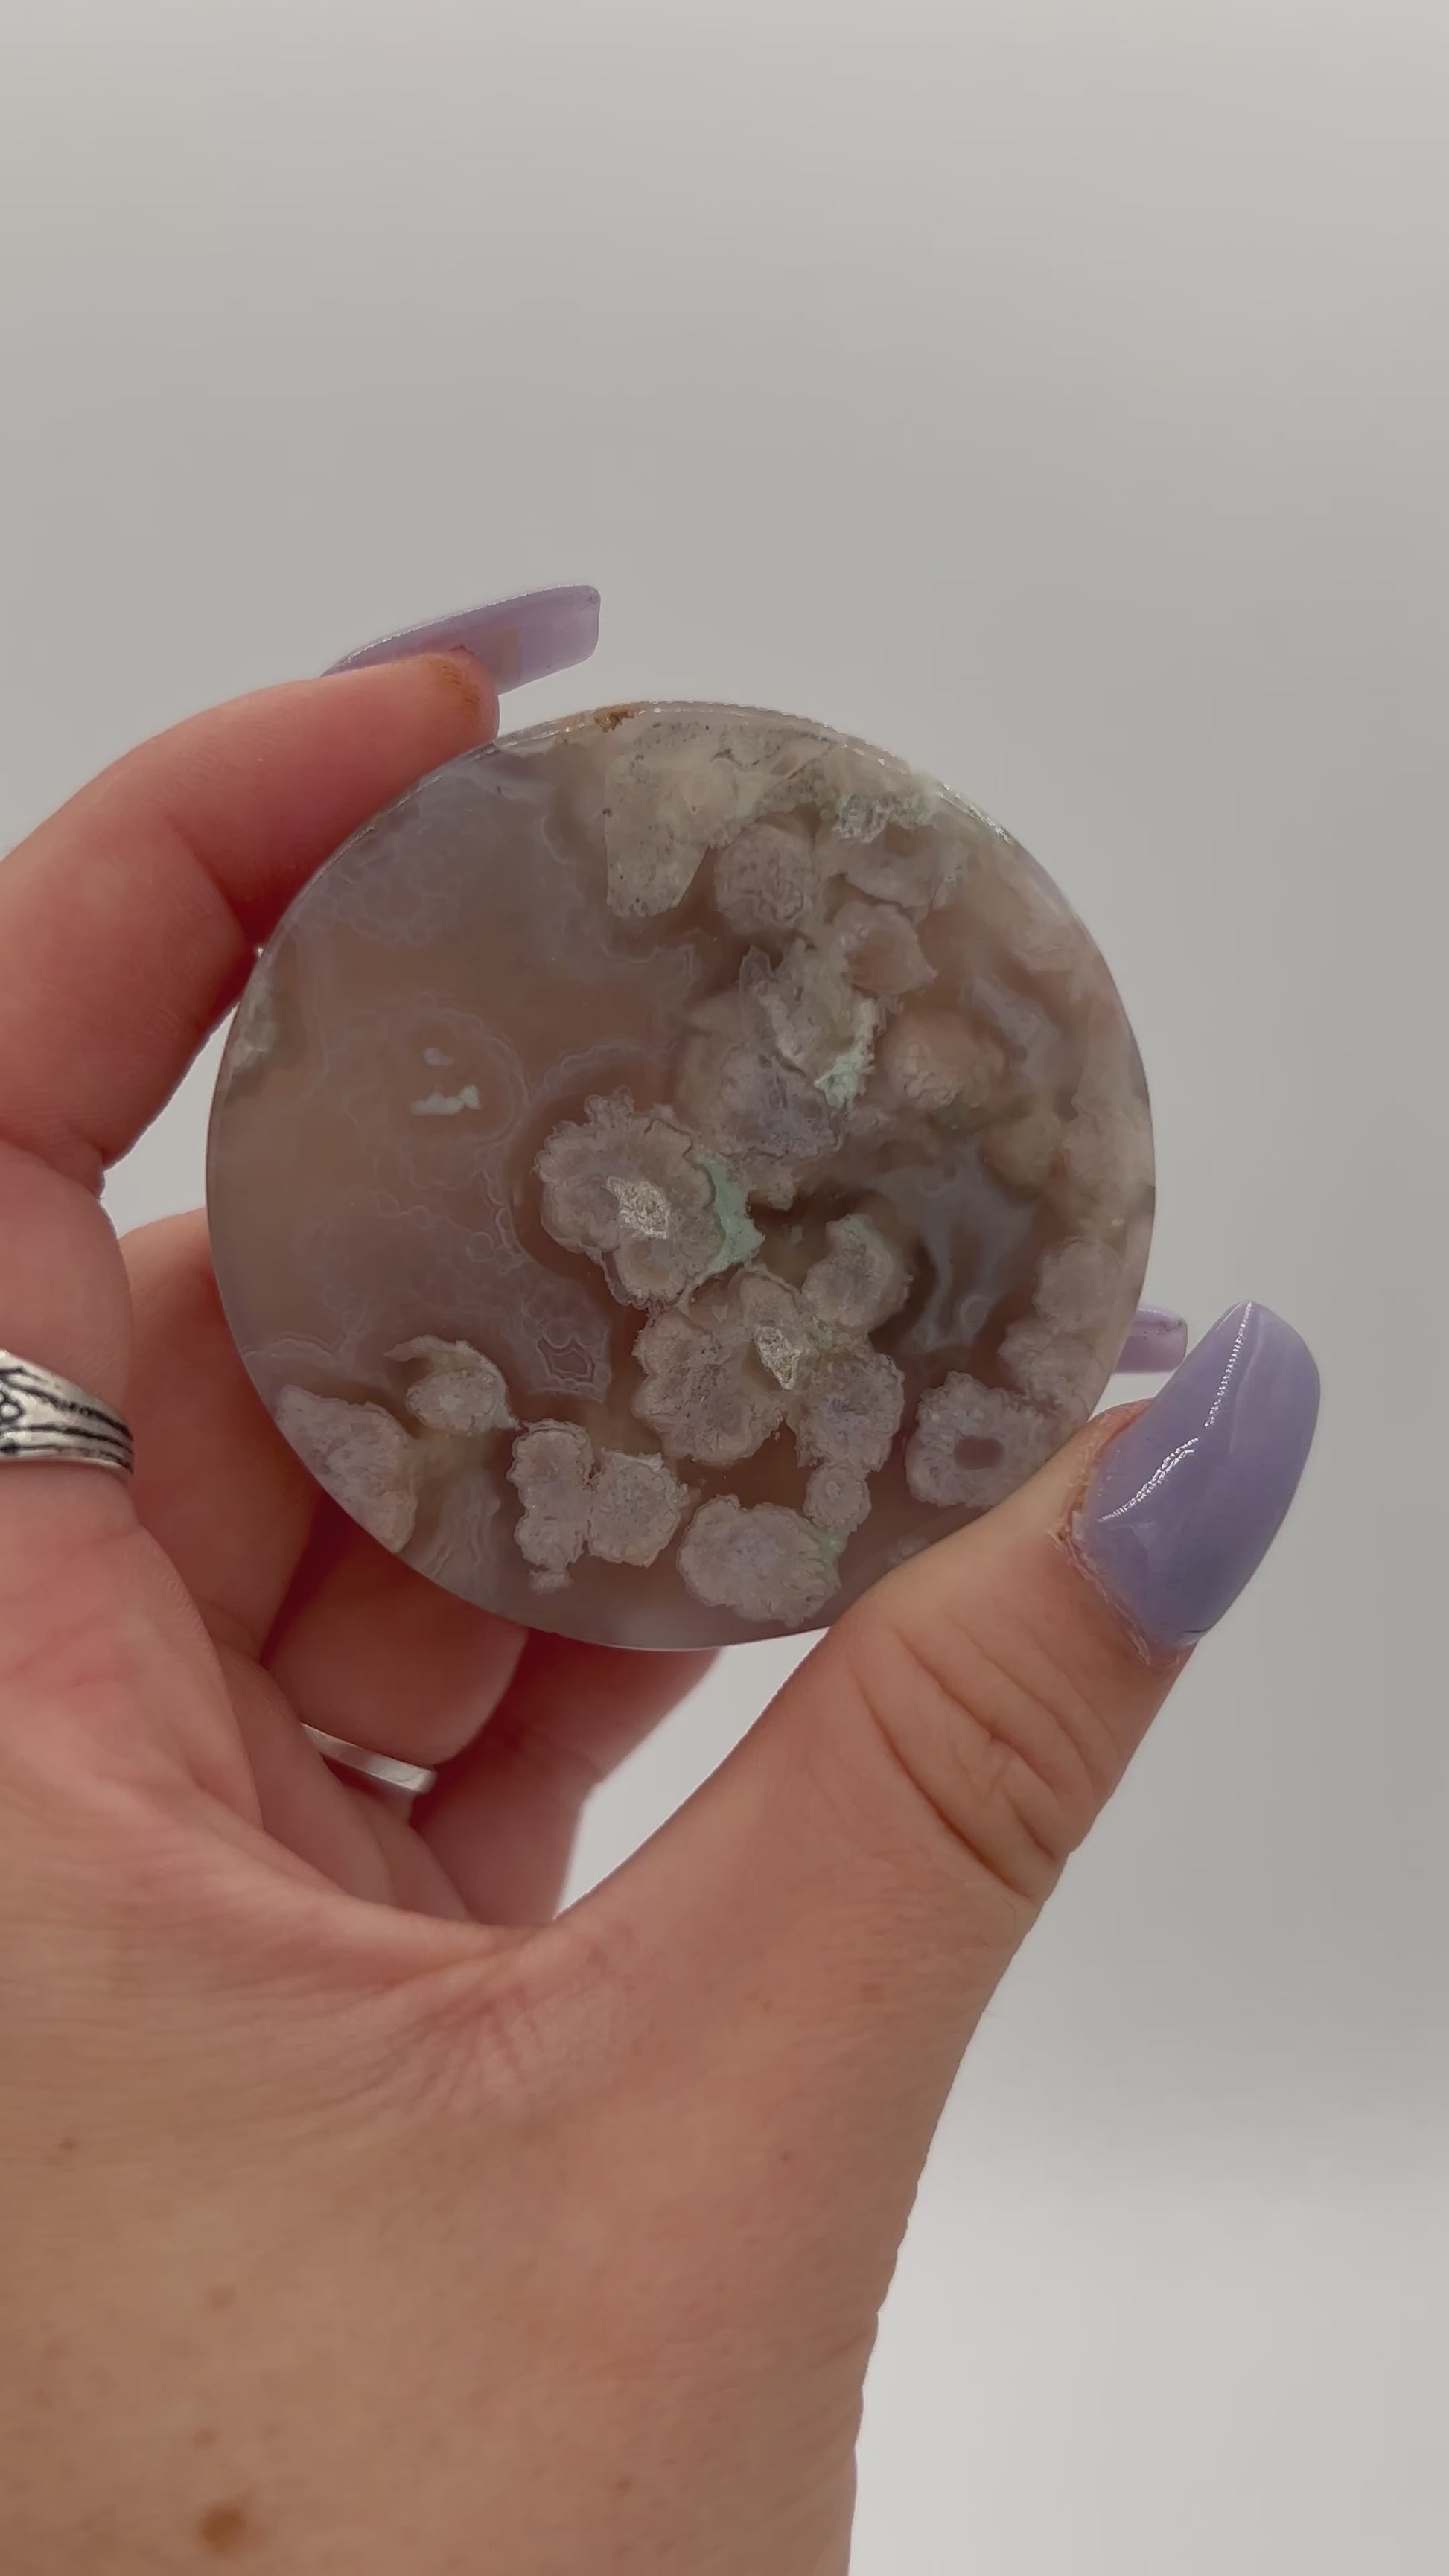
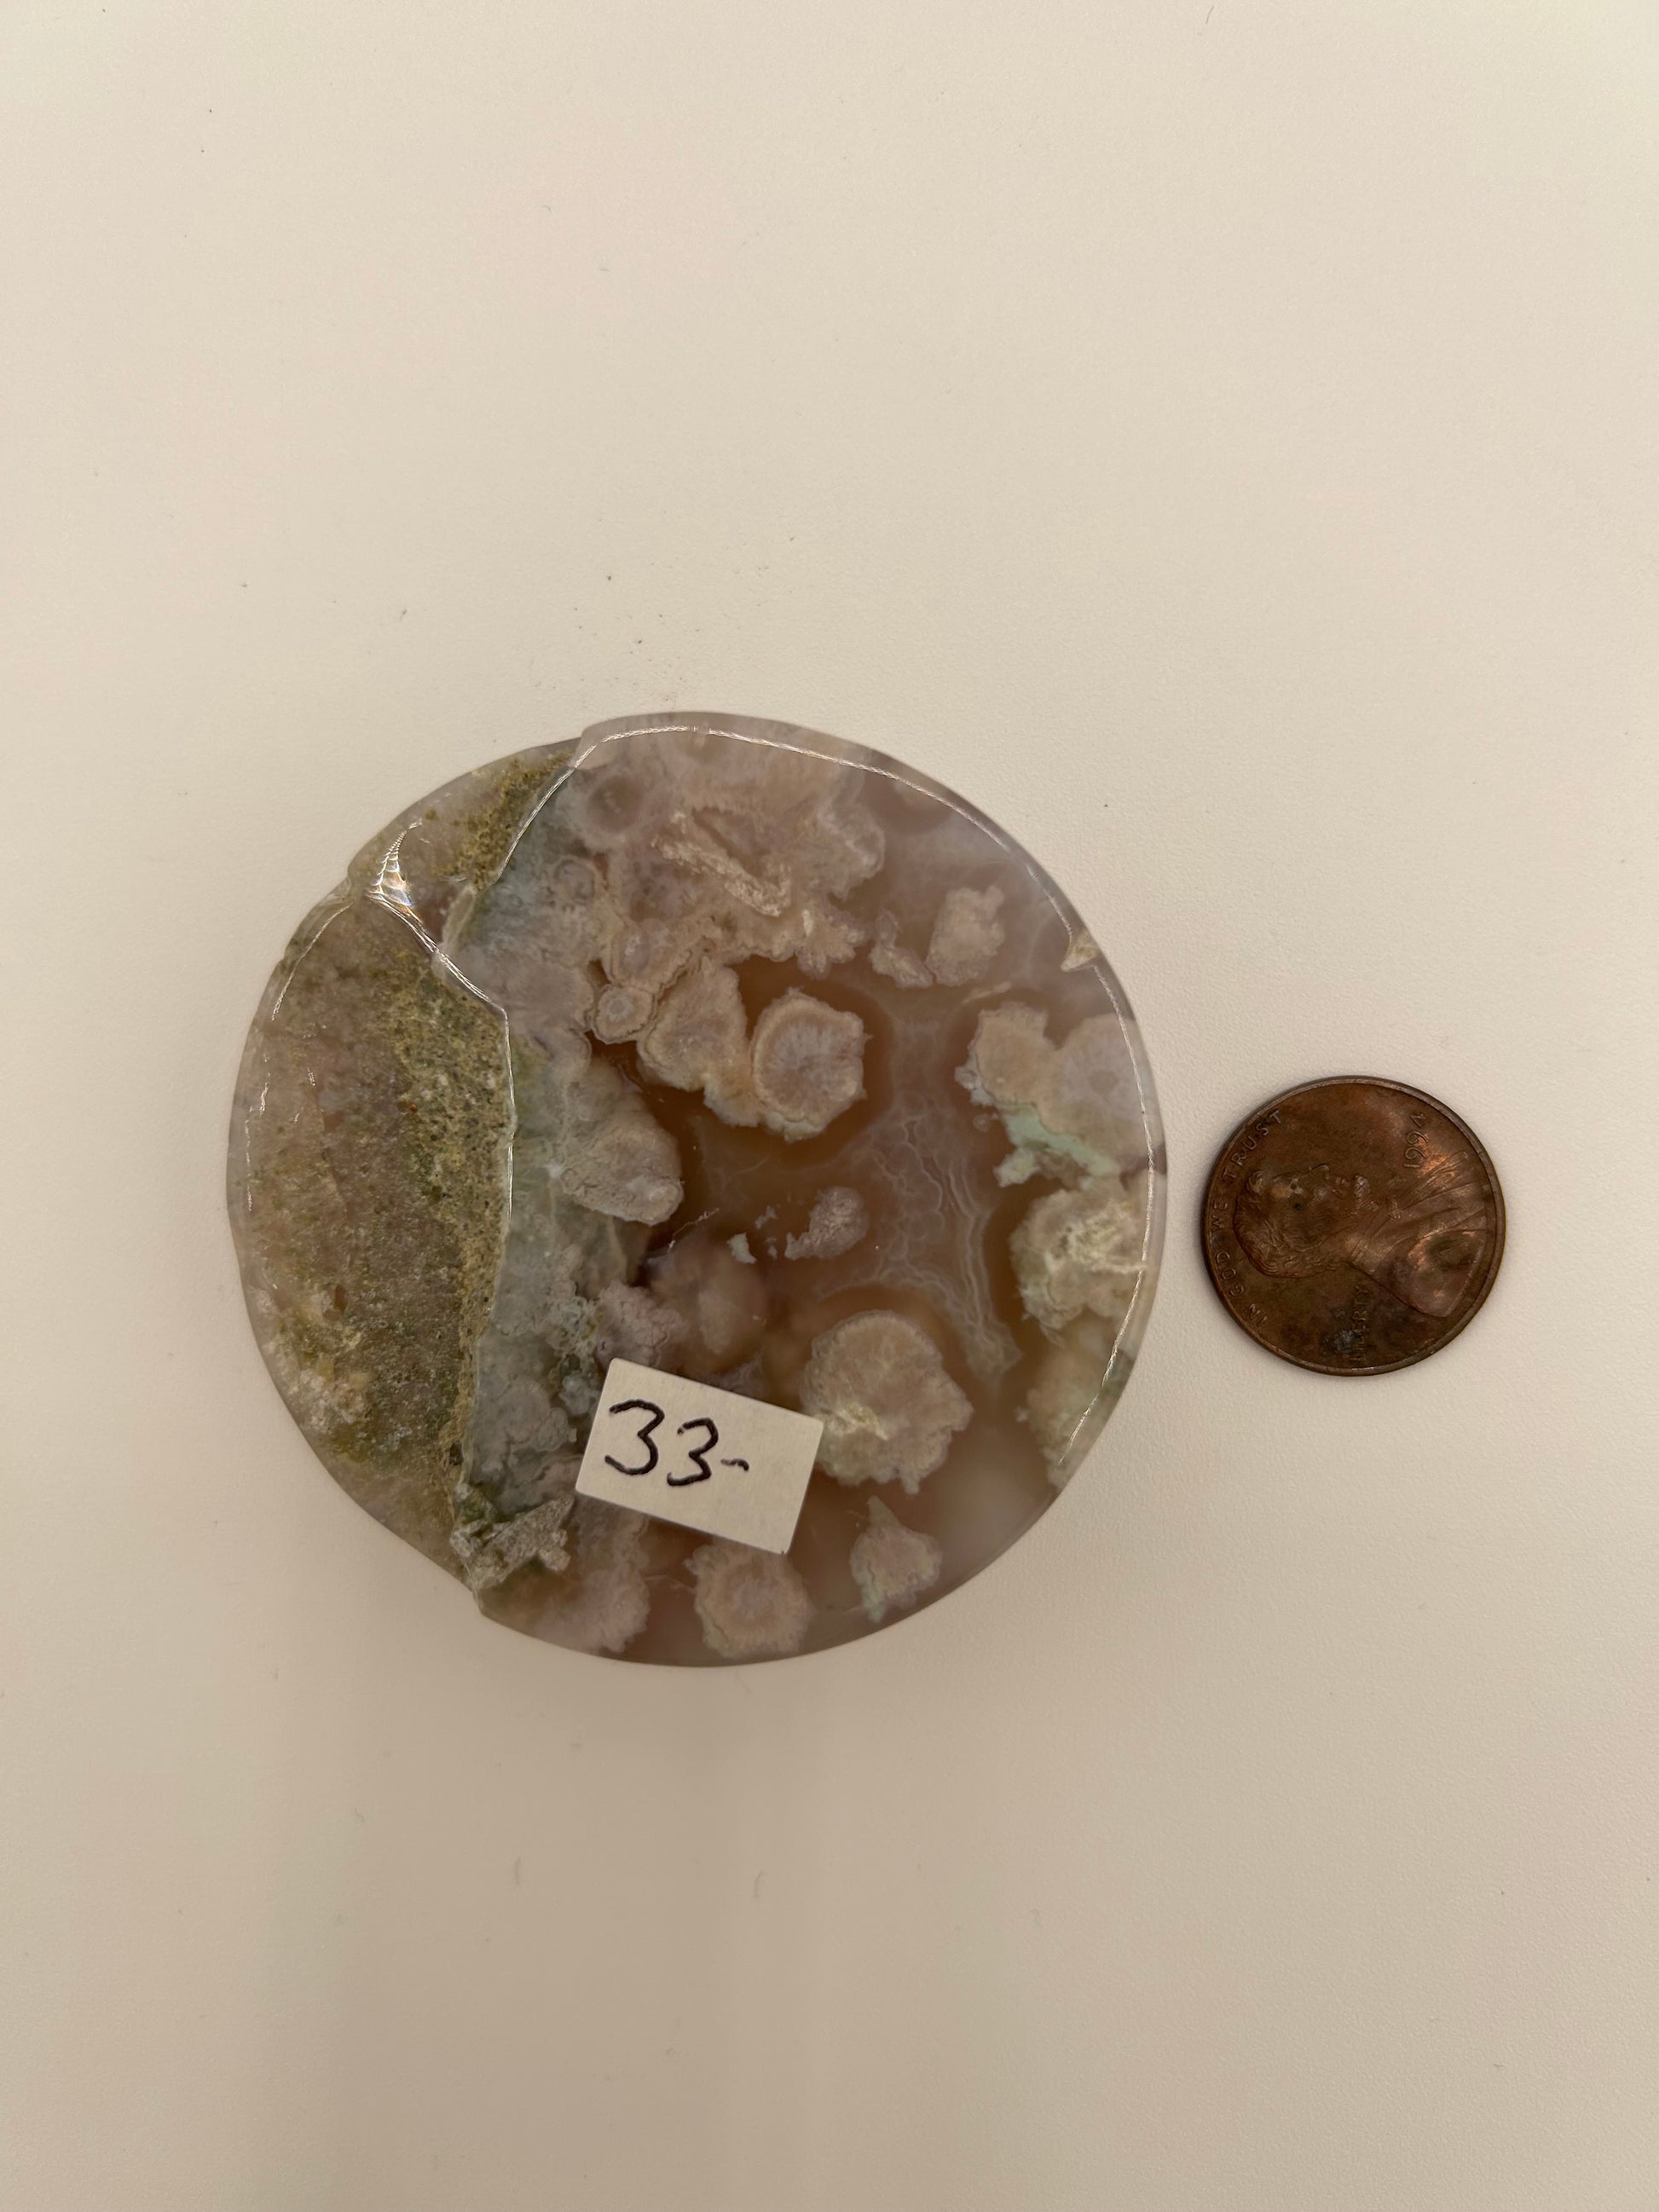

The Crystal Garden
Flower Agate Circle
Flower Agate Circle
Regular price
$33.00 USD
Regular price
Sale price
$33.00 USD
Unit price
per
Tax included.
Couldn't load pickup availability
Flower Agate Circle
Dimensions:
2.98 oz
5.5 cm x 1.3 cm
2.17 inches x .5"
Dimensions:
2.98 oz
5.5 cm x 1.3 cm
2.17 inches x .5"